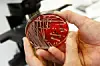
Arkivfoto: Cornelius Poppe/Scanpix.

Spædbørn og forældre smittet: 11 nye tilfælde af MRSA på dansk sygehus
Der er føjet 11 nye tilfælde til de tre fund af en MRSA-bakterie på Næstved Sygehus i sidste uge.
Podning af spædbørn på Næstved Sygehus har ført til, at der er fundet MRSA hos yderligere fire spædbørn. Desuden har syv forældre fået konstateret MRSA-bakterier.
I sidste uge kom det frem, at tre spædbørn på Næstved Sygehus var blevet smittet med en MRSA-bakterie.
Det oplyser Region Sjælland til TV Øst.
Der er ikke tale om den multiresistente MRSA-bakterie, som er kendt fra svin.
Alle har været indlagt på Neonatalafdelingen, som blandt andet behandler for tidligt fødte babyer og spædbørn med sygdomme.
De nye tilfælde af smitten blev konstateret, efter sygehuset iværksatte podning på alle de nyfødte børn.
Alle raske
De seneste tilfælde af børn og voksne er alle raske, og der er tale om børn, som alle var udskrevet eller er blevet udskrevet fra Neonatalafdelingen.
– Vi ved endnu ikke med sikkerhed, om alle de positivt testede børn og forældre bærer MRSA-bakterier af samme type, siger sygehusdirektør Vagn Bach til TV Øst.
– Men den type MRSA, som vi har fundet, kan behandles med antibiotika og kan fjernes helt fra spædbarnet igen.
– Men i de fleste tilfælde er en behandling ikke nødvendig, da MRSA-bakterien bliver udryddet af andre bakterier.
128 er undersøgt
I alt er 128 børn, forældre, pårørende og ansatte på nuværende tidspunkt blevet undersøgt for MRSA-bakterien. 148 personer venter stadig på at blive undersøgt for bakterien.
Der er ifølge Region Sjælland på nuværende tidspunkt ikke noget sundhedspersonale, som er blevet testet positive, skriver TV Øst.
Neonatalafdelingen på Næstved Sygehus lukkede ned, da det kom frem, at der var MRSA i omløb. Og det vil den blive ved med at være, indtil smitterisikoen er væk.
Selve fødselsafsnittet på Næstved Sygehus er ikke berørt af situationen.
/ritzau/












